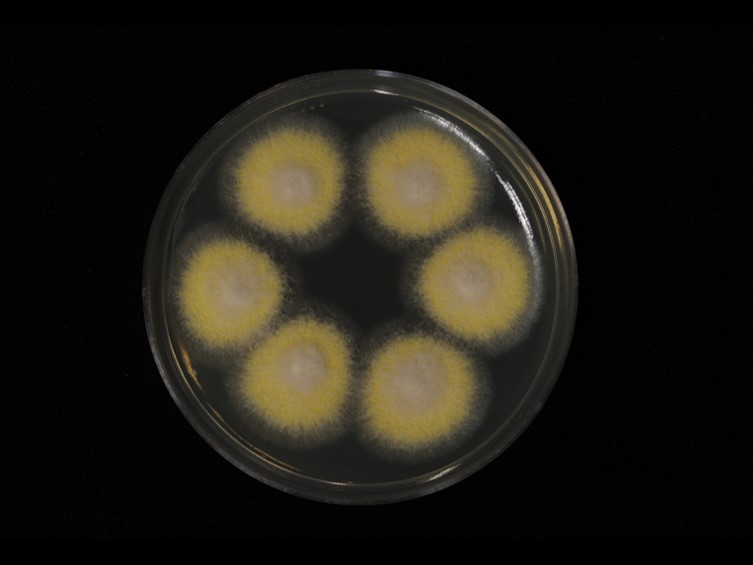

Habitat:
Underside of dicotyledonous leaves.
Host:
Whitefly nymphs (Aleyrodidae).
Description:
 Stromata dark red or mustard-yellow ca 1-3 mm in diam.
Stromata dark red or mustard-yellow ca 1-3 mm in diam.  Perithecia developing either on the edges of stroma, elongated flask-shaped to conical, bottom dark red to reddish-brown turing yellowish at the tip with ostioles hyaline or whitish, up to 1.2 mm long.
Perithecia developing either on the edges of stroma, elongated flask-shaped to conical, bottom dark red to reddish-brown turing yellowish at the tip with ostioles hyaline or whitish, up to 1.2 mm long.  Asci cylindrical, 450-600 × 4 μm.
Asci cylindrical, 450-600 × 4 μm.  Ascospores filliform, whole, 440-450 × 1 μm.
Ascospores filliform, whole, 440-450 × 1 μm.
Culture characteristics:
Colonies on PDA attaining 20–30 mm in diam after 14 d, white at first, turning cinnamon brown with age, producing the Paecilomyces anamorph in culture.
Colonies on PDA attaining 20–30 mm in diam after 14 d, white at first, turning cinnamon brown with age, producing the Paecilomyces anamorph in culture.
Other Available strains
TBRC 3783 , TBRC 3894 , TBRC 8476Reference:
Hywel-Jones NL (1993). Torrubiella luteorostrata, a pathogen of scale insects and its association with Paecilomyces cinnamomeus with a note on Torrubiella tenuis. Mycological Research 97: 1126–1130.
DOI: https://doi.org/10.1016/S0953-7562(09)80514-5Johnson D, Sung G-H, Hywel-Jones NL, et al. (2009). Systematics and evolution of the genus Torrubiella (Hypocreales, Ascomycota). Mycological Research 113: 279–289.
DOI: https://doi.org/10.1016/j.mycres.2008.09.008Sung, G-H, Hywel-Jones NL, Sung J-M, et al. (2007). Phylogenetic classification of Cordyceps and the clavicipitaceous fungi. Studies in Mycology __57: 5–59.
DOI: https://doi.org/10.3114/sim.2007.57.01Zimmermann A (1901). Einige javanische auf Cocciden parasitierende Ascomyceten. Zentralbl. Bakt. ParasitKde. Zweite Abt.7: 872.
Species |
Strain |
Compound |
Pubchem CID |
Biological activity |
Reference |
|---|---|---|---|---|---|
| Conoideocrella luteorostrata | TBRC 3894 | 6'-(4''-O-methyl-β-glucopyranoside) derivative of ES-242-1 (1) | 159931 | Antimicrobial acitvity against S. aureus; Antimicrobial acitvity against E. coli | Saepua et al. 2015 |
| Conoideocrella luteorostrata | TBRC 3894 | 9-(4'-O-methyl-β-glucopyranoside) analogue of 25 (10) | 159931 | Antimicrobial acitvity against S. aureus; Antimicrobial acitvity against E. coli | Saepua et al. 2015 |
| Conoideocrella luteorostrata | TBRC 3894 | 4-(4'-O-methyl-β-glucopyranoside) derivative of 19 (11) | 159931 | Antimicrobial acitvity against S. aureus; Antimicrobial acitvity against E. coli | Saepua et al. 2015 |
| Conoideocrella luteorostrata | TBRC 3894 | Monomer of 23 (12) | 159931 | Antimicrobial acitvity against S. aureus; Antimicrobial acitvity against E. coli | Saepua et al. 2015 |
| Conoideocrella luteorostrata | TBRC 3894 | 9-(4'-O-methyl-β-glucopyranoside) derivative of 12 (13) | 159931 | Antimicrobial acitvity against S. aureus; Antimicrobial acitvity against E. coli | Saepua et al. 2015 |
| Conoideocrella luteorostrata | TBRC 3894 | Compound 14, related to 25 (14) | 159931 | Antimicrobial acitvity against S. aureus; Antimicrobial acitvity against E. coli | Saepua et al. 2015 |
| Conoideocrella luteorostrata | TBRC 3894 | 9-(4'-O-methyl-β-glucopyranoside) derivative of 14 (15) | 159931 | Antimicrobial acitvity against S. aureus; Antimicrobial acitvity against E. coli | Saepua et al. 2015 |
| Conoideocrella luteorostrata | TBRC 3894 | 10-hydroxyl analogue of 15 (16) | 159931 | Antimicrobial acitvity against S. aureus; Antimicrobial acitvity against E. coli | Saepua et al. 2015 |
| Conoideocrella luteorostrata | TBRC 3894 | 8-(4'-O-methyl-D-glucopyranoside) analogue of 18 (17) | 159931 | Antimicrobial acitvity against S. aureus; Antimicrobial acitvity against E. coli | Saepua et al. 2015 |
| Conoideocrella luteorostrata | TBRC 3894 | Compound 18 Saepua et al 2015 (18) | 159931 | Antimicrobial acitvity against S. aureus; Antimicrobial acitvity against E. coli | Saepua et al. 2015 |
| Conoideocrella luteorostrata | TBRC 3894 | Compound 19 Saepua et al 2015 (19) | 159931 | Antimicrobial acitvity against S. aureus; Antimicrobial acitvity against E. coli | Saepua et al. 2015 |
| Conoideocrella luteorostrata | TBRC 3894 | Atropisomer of bioxanthracene 20 (2) | 159931 | Antimicrobial acitvity against S. aureus; Antimicrobial acitvity against E. coli | Saepua et al. 2015 |
| Conoideocrella luteorostrata | TBRC 3894 | Bioxanthracene derivative (20) | 159931 | Antimicrobial acitvity against S. aureus; Antimicrobial acitvity against E. coli | KNOWN: Isaka et al. 2001 (6) |
| Conoideocrella luteorostrata | TBRC 3894 | ES-242-1 (21) | 159931 | Antimicrobial acitvity against S. aureus; Antimicrobial acitvity against E. coli | KNOWN: Isaka et al. 2001 (6) |
| Conoideocrella luteorostrata | TBRC 3894 | ES-242-2 (22) | 159931 | Antimicrobial acitvity against S. aureus; Antimicrobial acitvity against E. coli | KNOWN: Isaka et al. 2001 (6) |
| Conoideocrella luteorostrata | TBRC 3894 | Atropisomer of ES-242-2 (23) | 159931 | Antimicrobial acitvity against S. aureus; Antimicrobial acitvity against E. coli | KNOWN: Isaka et al. 2001 (6) |
| Conoideocrella luteorostrata | TBRC 3894 | Bioxanthracene derivative (24) | 159931 | Antimicrobial acitvity against S. aureus; Antimicrobial acitvity against E. coli | KNOWN: Isaka et al. 2001 (6) |
| Conoideocrella luteorostrata | TBRC 3894 | Monomer (25) | 159931 | Antimicrobial acitvity against S. aureus; Antimicrobial acitvity against E. coli | KNOWN: Isaka et al. 2001 (13) |
| Conoideocrella luteorostrata | TBRC 3894 | Hopane-6β,7β,22-triol (26) | 159931 | Antimicrobial acitvity against S. aureus; Antimicrobial acitvity against E. coli | KNOWN: Isaka et al. 2001 (13) |
| Conoideocrella luteorostrata | TBRC 3894 | Zeorin (27) | 159931 | Antimicrobial acitvity against S. aureus; Antimicrobial acitvity against E. coli | KNOWN: Isaka et al. 2001 (13) |
| Conoideocrella luteorostrata | TBRC 8476 | Conoideoxime A (28) | 159931 | Antimicrobial acitvity against S. aureus; Antimicrobial acitvity against E. coli | Isaka et al. 2019 |
| Conoideocrella luteorostrata | TBRC 8476 | Terezine D (29): Sporormiella teretispora | 159931 | Antimicrobial acitvity against S. aureus; Antimicrobial acitvity against E. coli | KNOWN: Wang et al. 1995 |
| Conoideocrella luteorostrata | TBRC 3894 | Compound 3 Saepua et al 2015 (3) | 159931 | Antimicrobial acitvity against S. aureus; Antimicrobial acitvity against E. coli | Saepua et al. 2015 |
| Conoideocrella luteorostrata | TBRC 3783 | Paecilodepsipeptide A (30) | 159931 | Antimicrobial acitvity against S. aureus; Antimicrobial acitvity against E. coli | Isaka et al. 2007 |
| Conoideocrella luteorostrata | TBRC 3783 | Paecilodepsipeptide B (31) | 159931 | Antimicrobial acitvity against S. aureus; Antimicrobial acitvity against E. coli | Isaka et al. 2007 |
| Conoideocrella luteorostrata | TBRC 3783 | Paecilodepsipeptide C (32) | 159931 | Antimicrobial acitvity against S. aureus; Antimicrobial acitvity against E. coli | Isaka et al. 2007 |
| Conoideocrella luteorostrata | TBRC 8476 | Paecilodepsipeptide D (33) | 159931 | Antimicrobial acitvity against S. aureus; Antimicrobial acitvity against E. coli | Isaka et al. 2019b |
| Conoideocrella luteorostrata | TBRC 3894 | Compound 4 Saepua et al 2015 (4) | 159931 | Antimicrobial acitvity against S. aureus; Antimicrobial acitvity against E. coli | Saepua et al. 2015 |
| Conoideocrella luteorostrata | TBRC 3894 | Atropisomer of 6'-(4''-O-methyl-β-glucopyranoside) derivative of ES-242-1 (5) | 159931 | Antimicrobial acitvity against S. aureus; Antimicrobial acitvity against E. coli | Saepua et al. 2015 |
| Conoideocrella luteorostrata | TBRC 3894 | Compound 6 Saepua et al 2015 (6) | 159931 | Antimicrobial acitvity against S. aureus; Antimicrobial acitvity against E. coli | Saepua et al. 2015 |
| Conoideocrella luteorostrata | TBRC 3894 | Atropisomer of 6 (7) | 159931 | Antimicrobial acitvity against S. aureus; Antimicrobial acitvity against E. coli | Saepua et al. 2015 |
| Conoideocrella luteorostrata | TBRC 3894 | Atropisomer of bioxanthracene 24 (8) | 159931 | Antimicrobial acitvity against S. aureus; Antimicrobial acitvity against E. coli | Saepua et al. 2015 |
| Conoideocrella luteorostrata | TBRC 3894 | 6-(4'-O-methyl-β-glucopyranoside) analogue of 25 (9) | 159931 | Antimicrobial acitvity against S. aureus; Antimicrobial acitvity against E. coli | Saepua et al. 2015 |
|
Strain |
LSU | TEF1 |
|---|---|---|
| BCC 53671 | KJ435072 | KJ435088 |
| BCC 53672 | KJ435073 | KJ435089 |
| BCC 53673 | KJ435074 | KJ435091 |
| BCC 53675 | KJ435075 | KJ435096 |
| BCC 53677 | KJ435077 | KJ435090 |